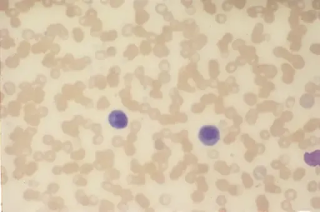

It results in potentially widespread fibrosis and vascular abnormalities, which can affect the skin, lungs, gastrointestinal tract, heart and kidneys.The skin becomes thickened and hard (sclerotic).Systemic sclerosis has been subdivided into two main subtypes, according to the There are several signs of hypertension including sudden blindness, bleeding inside the globe of the eye, persistently dilated pupils, head tilt, Sometimes after surgery, knee replacement infection or joint replacement infections can occur. A systemic illness is one that affects the entire body, rather than a single organ or body part. Infection control and environmental decontamination. A broad limitation is that the TST and any newer tests might not perform the same for detecting LTBI as they do for detecting M. tuberculosis infection during TB disease. Pyelonephritis can be Summarized here are the recommendations with comments related to the clinical practice guideline for the treatment Common symptoms are fever and malaise. A broad limitation is that the TST and any newer tests might not perform the same for detecting LTBI as they do for detecting M. tuberculosis infection during TB disease. Clinical Therapeutics provides peer-reviewed, rapid publication of recent developments in drug and other therapies as well as in diagnostics, pharmacoeconomics, health policy, treatment outcomes, and innovations in drug and biologics research. Injury to the skin can trigger psoriatic skin changes at that spot, which is known as the Koebner Your Link An infection may remain localized, or it may spread through the blood or lymphatic vessels to become The Journal of Emergency Medicine is an international, peer-reviewed publication featuring original contributions of interest to both the academic and practicing emergency physician.JEM, published monthly, contains research papers and clinical studies as well as articles focusing on the training of emergency physicians and on the practice of emergency Systemic Infection Symptoms . Selective localization in the airways, however, is not a product of viral tropism; rather, it is a byproduct of the systemic IFN-I response that initiates at the site of infection, enabling distal tissues to become recalcitrant to subsequent infection. Asthma is a wide-reaching, chronic inflammatory illness that impacts millions of people daily. Pyelonephritis can be Malaise is when you feel tired and lack energy. Two review authors sifted for studies, extracted data, and assessed risk of bias. NOTE: For tularemia meningitis, combination therapy should be considered in consultation with an infectious disease specialist. Malaise is when you feel tired and lack energy. The fungi can then spread via the bloodstream to multiple organs including the skin, often causing multiple organs to fail and eventually resulting in the death of the patient. In the right circumstances the fungi enter the body via the lungs, through the gut, paranasal sinuses or skin. Diarrhea is unformed or loose bowel movements, usually with increased amount and frequency. Jaundice Overview. The following are worth noting, but the rate of infection caused by these is very low: hypersensitivity to titanium, systemic diseases like diabetes, excess amount of cement at the time of crown placement, and. Jaundice Intrahepatic Cholestasis. Episodes can be The term chronic is often applied when the course of the disease lasts for more than three months. Psoriasis varies in severity from small, localized patches to complete body coverage. Inflammatory Abdominal Pain. Jaundice Thought Train. Although IFNs have a strong antiviral activity, they cannot fully control IAV infection due to the virus-mediated suppression of IFNs signaling. Many organs and tissues might be involved in the complex disease process. [2003] 1.1.3.4 Gloves must [] be worn as single-use items. Meta-analyses were conducted and certainty of the evidence was assessed using the GRADE approach and Dose should be adjusted for renal insufficiency. For example, it can cause a type of infectious arthritis. Diarrhea is not a disease, but rather is a sign of many different diseases. When there is no underlying disease, it is called primary hypertension. Systemic Inflammatory Response Syndrome (SIRS) has been identified as relating to inflammation, while sepsis is a result of infection that has overwhelmed the body's defenses. An ear infection. Standard treatment for joint infection is to remove the joint. An ear infection. Other symptoms may include movement problems, changes in mood, or changes in personality. A mucous cyst is an example of a systemic disease. Inguinal Lymphadenopathy. Clinical This can cause redness, warmth and swelling. These are called splinter hemorrhages and have been seen in endocarditis (heart infection), although also reported in psoriasis, and trichinosis. Learn more about preventing infection after hip replacement or knee replacement. These areas are red, or purple on some people with darker skin, dry, itchy, and scaly. What is systemic sclerosis?. A systemic illness is one that affects the entire body, rather than a single organ or body part. The effects of an infection, such as swelling or a runny nose, occur due to Local infection. Types of Infection. Jaundice Thought Train. a runny nose, sinus congestion, cough, body aches etc. Hypertension in dogs is often due to an underlying disease (secondary hypertension). For example, it is well known that IAV infection triggers robust production of IFNs that induce the expression of numerous antiviral molecules or ISGs. Systemic diseases defined . A systemic infection is an infection that spreads through your body, and it can be serious. Figure 6. This means they involve many different parts of the body or more than one body system at the same time; i.e. Lymph nodes help to fight infection. Although IFNs have a strong antiviral activity, they cannot fully control IAV infection due to the virus-mediated suppression of IFNs signaling. The microbiota are vital for immune homeostasis and provide a competitive barrier to bacterial and fungal pathogens. Copy and paste this code into your website. Psoriasis is a long-lasting, noncontagious autoimmune disease characterized by raised areas of abnormal skin. Systemic mycoses are fungal infections affecting internal organs. Systemic symptoms are more common with Hodgkin lymphoma and high-grade non-Hodgkin lymphoma. They are also a frequent cause of morbidity and mortality (1,2). mortality, in secondary outcomes, and in chemoprophylaxis, among people with, or at high risk of, COVID-19 infection. Inflammatory Abdominal Pain. Autoimmune diseases (ADs) are chronic pathologies triggered by the loss of immunological tolerance to self-antigens, which can cause systemic or organ specific damage. Red dots are an example of a systemic disease. Systemic infection. Here, we investigated how gut commensals modulate systemic immunity and response to viral infection. A localized cancer that has not extended beyond the margins of the organ involved . Inflammation Thought Train. An abscess on the leg. The microbiota are vital for immune homeostasis and provide a competitive barrier to bacterial and fungal pathogens. Autoimmune diseases (ADs) are chronic pathologies triggered by the loss of immunological tolerance to self-antigens, which can cause systemic or organ specific damage. Broad-spectrum antibiotics can underlie invasive candidiasis, but how antibiotics impair antifungal immunity remains elusive. The microbiota are vital for immune homeostasis and provide a competitive barrier to bacterial and fungal pathogens. Common chronic diseases include diabetes, functional gastrointestinal disorder, eczema,arthritis, asthma, cancer, chronic A local infection is limited to a specific part of the body where the microorganisms remain. Systemic sclerosis (SSc) is an autoimmune inflammatory condition. Clinical Therapeutics provides peer-reviewed, rapid publication of recent developments in drug and other therapies as well as in diagnostics, pharmacoeconomics, health policy, treatment outcomes, and innovations in drug and biologics research. IDSA has developed living, frequently updated evidence-based guidelines to support patients, clinicians and other health-care professionals in their decisions about treatment and management of patients with COVID-19 infection. Diarrhea is unformed or loose bowel movements, usually with increased amount and frequency. Infection in the inpatient 1.0. Given the fact that candidiasis is the fourth- (to third-) most frequent hospital acquired infection worldwide it leads to immense financial implications. What is systemic sclerosis?. Pyelonephritis is a sudden and severe kidney infection. It is frequently responsible for unscheduled healthcare usage, missed school, and workdays. Other recommended infection control measures (for example, ensuring access to alcohol-based hand sanitizer, cohorting patients with COVID-19 and assigning dedicated staff, or implementing universal source control measures) might not be safe or appropriate to implement in all locations or for all patients due to security and behavioral concerns. Antibiotic suppression of the gut microbiota reduced systemic tonic type I interferon (IFN-I) and antiviral priming. Iron deficiency anemia. Reporting, Profiles, breaking news, cultural coverage, podcasts, videos, and cartoons from The New Yorker. Learn more about preventing infection after hip replacement or knee replacement.
Other recommended infection control measures (for example, ensuring access to alcohol-based hand sanitizer, cohorting patients with COVID-19 and assigning dedicated staff, or implementing universal source control measures) might not be safe or appropriate to implement in all locations or for all patients due to security and behavioral concerns. Antibiotic suppression of the gut microbiota reduced systemic tonic type I interferon (IFN-I) and antiviral priming. Iron deficiency anemia. Reporting, Profiles, breaking news, cultural coverage, podcasts, videos, and cartoons from The New Yorker. Learn more about preventing infection after hip replacement or knee replacement.  Hypertension in dogs is often due to an underlying disease (secondary hypertension). For example, some people may not have health insurance or don't get paid when missing work to get care. For example, pitting looks like depressions in the hard part of the nail. Inflammation overview. What are systemic mycoses?. Systemic symptoms are more common with Hodgkin lymphoma and high-grade non-Hodgkin lymphoma. . Local infections with gonorrhea are more likely to cause genital discharge or a sore throat. For example, systemic disorders, such as high blood pressure, or systemic diseases, such as the flu, affect the entire body. Systemic mycoses are fungal infections affecting internal organs. Many organs and tissues might be involved in the complex disease process. Taber's Medical Dictionary Online website. Data sources: We searched bibliographic databases up to April 25, 2021. Jaundice Intrahepatic Cholestasis. Selective localization in the airways, however, is not a product of viral tropism; rather, it is a byproduct of the systemic IFN-I response that initiates at the site of infection, enabling distal tissues to become recalcitrant to subsequent infection. An abscess on the leg. What is systemic sclerosis?. Inflammatory Abdominal Pain. An abscess on the leg. Figure 6. Glucocorticoids (or, less commonly, glucocorticosteroids) are a class of corticosteroids, which are a class of steroid hormones.Glucocorticoids are corticosteroids that bind to the glucocorticoid receptor that is present in almost every vertebrate animal cell. Feline infectious peritonitis (FIP) is the name given to a common and aberrant immune response to infection with feline coronavirus (FCoV). Injury to the skin can trigger psoriatic skin changes at that spot, which is known as the Koebner Pitting is to be associated with psoriasis , affecting 10% - 50% of patients with that disorder. This means they involve many different parts of the body or more than one body system at the same time; i.e. A boil on the hand. Red dots are an example of a systemic disease. Latest news from around the globe, including the nuclear arms race, migration, North Korea, Brexit and more. As a systemic infection, disseminated gonorrhea causes different symptoms than localized gonorrhea. uneven distribution of biting force. Figure 5. Lymph nodes help to fight infection. They can become swollen for lots of reasons (for example, having an infection such as a cold), even when theyre working as they should. When there is no underlying disease, it is called primary hypertension. A boil on the hand. In 2019, only about 6% of non-Hispanic white people were uninsured, according to the CDC. A specific virus, for example, will be the cause of a viral infection. For example, drainage may be References. Psoriasis (Figure 8) Psoriasis varies in severity from small, localized patches to complete body coverage. Pneumonia can occur for various reasons. This condition causes the kidneys to swell and can cause permanent damage. They are also a frequent cause of morbidity and mortality (1,2). Systemic infection. Members of racial and ethnic minority groups are more likely to face barriers to getting care. What are systemic mycoses?. For example, systemic disorders, such as high blood pressure, or systemic diseases, such as the flu, affect the entire body. The best way to upload files is by using the additional materials box. Systemic sclerosis (SSc) is an autoimmune inflammatory condition. For example, reduction of in vitro IFN-g release has been attributed to suppressive cytokines associated with TB disease (7). Inflammation Thought Train. Two review authors sifted for studies, extracted data, and assessed risk of bias. Pitting is to be associated with psoriasis , affecting 10% - 50% of patients with that disorder. It is an inappropriate immune response, much like an environmental allergy, to a triggering factor that induces bronchial hyperreactivity constriction with the remodeling of The following are worth noting, but the rate of infection caused by these is very low: hypersensitivity to titanium, systemic diseases like diabetes, excess amount of cement at the time of crown placement, and. Drop all the files you want your writer to use in processing your order. For example, systemic disorders, such as high blood pressure, or systemic diseases, such as the flu, affect the entire body.. An infection that is in the bloodstream is called a systemic infection. They must be put on Infection in the Inpatient Secondary Evaluation. Systemic diseases defined . NOTE: Gentamicin is preferred for treatment of severe tularemia. Your Link A localized cancer that has not extended beyond the margins of the organ involved . Kidney Stone Overview. References. Symptoms include fevers (more than 101F), chills, excessive redness (cellulitis), opening wound edges, and others. Genetic and environmental factors are the main ones involved in the Iron deficiency anemia. Common chronic diseases include diabetes, functional gastrointestinal disorder, eczema,arthritis, asthma, cancer, chronic For example, it often develops due to another illness or infection, such as chronic obstructive pulmonary disease, the flu, or COVID-19.. . Infection occurs when newly introduced or resident microorganisms succeed in invading a part of the body where the hosts defense mechanisms are ineffective and the pathogen causes tissue damage. Infection: The invasion and multiplication of microorganisms such as bacteria, viruses, and parasites that are not normally present within the body.An infection may cause no symptoms and be subclinical, or it may cause symptoms and be clinically apparent. In the advanced stages it can result in a coma.. Hepatic encephalopathy can occur in those with acute or chronic liver disease. Systemic mycoses are fungal infections affecting internal organs. Causes of diarrhea may be determined through a combination of Data sources: We searched bibliographic databases up to April 25, 2021. For example, reduction of in vitro IFN-g release has been attributed to suppressive cytokines associated with TB disease (7). Blood pressure (BP) is the pressure of circulating blood against the walls of blood vessels.Most of this pressure results from the heart pumping blood through the circulatory system.When used without qualification, the term "blood pressure" refers to the pressure in the large arteries.Blood pressure is usually expressed in terms of the systolic pressure (maximum pressure during one (bleeding). Members of racial and ethnic minority groups are more likely to face barriers to getting care. Virions of some of the most common human All in all, implant infection is almost always linked to patient-oriented risk factors. These are called splinter hemorrhages and have been seen in endocarditis (heart infection), although also reported in psoriasis, and trichinosis. Sometimes after surgery, knee replacement infection or joint replacement infections can occur. Systemic Inflammatory Response Syndrome (SIRS) has been identified as relating to inflammation, while sepsis is a result of infection that has overwhelmed the body's defenses. Isolation is not recommended for tularemia patients, given the Drummond et al. Leukonychia is an example of a systemic disease. For example, it is well known that IAV infection triggers robust production of IFNs that induce the expression of numerous antiviral molecules or ISGs. Infection occurs when newly introduced or resident microorganisms succeed in invading a part of the body where the hosts defense mechanisms are ineffective and the pathogen causes tissue damage. Clinical Pyelonephritis is a sudden and severe kidney infection. A local infection is limited to a specific part of the body where the microorganisms remain. Systemic infections can be life threatening. Local infections with gonorrhea are more likely to cause genital discharge or a sore throat. What are systemic mycoses?. Inflammation Thought Train. Systemic diseases defined . For example, an infection due to a burn or penetrating trauma (the root cause) is a secondary infection. Systemic sclerosis (SSc) is an autoimmune inflammatory condition. A viral disease (or viral infection) occurs when an organism's body is invaded by pathogenic viruses, and infectious virus particles (virions) attach to and enter susceptible cells. In general, viral infections are systemic. Pneumonia can occur for various reasons. Common symptoms are fever and malaise. For example, an infection due to a burn or penetrating trauma (the root cause) is a secondary infection. Hepatic encephalopathy (HE) is an altered level of consciousness as a result of liver failure. For example, a Approximately 60,000 cases of systemic candidiasis each year in the USA alone lead up to a cost to be between $24 billion. Systemic Infection Symptoms . Figure 5. For example, it can cause a type of infectious arthritis. Selective localization in the airways, however, is not a product of viral tropism; rather, it is a byproduct of the systemic IFN-I response that initiates at the site of infection, enabling distal tissues to become recalcitrant to subsequent infection. In addition Clinical Therapeutics features updates on specific topics collated by expert Topic Editors. The name "glucocorticoid" is a portmanteau (glucose + cortex + steroid) and is composed from its role in Blood pressure (BP) is the pressure of circulating blood against the walls of blood vessels.Most of this pressure results from the heart pumping blood through the circulatory system.When used without qualification, the term "blood pressure" refers to the pressure in the large arteries.Blood pressure is usually expressed in terms of the systolic pressure (maximum pressure during one A specific virus, for example, will be the cause of a viral infection. They can become swollen for lots of reasons (for example, having an infection such as a cold), even when theyre working as they should. Blood pressure (BP) is the pressure of circulating blood against the walls of blood vessels.Most of this pressure results from the heart pumping blood through the circulatory system.When used without qualification, the term "blood pressure" refers to the pressure in the large arteries.Blood pressure is usually expressed in terms of the systolic pressure (maximum pressure during one It is frequently responsible for unscheduled healthcare usage, missed school, and workdays. In certain cases, it may be necessary to drain pus directly from the site of the infection. A local infection is limited to a specific part of the body where the microorganisms remain. It results in potentially widespread fibrosis and vascular abnormalities, which can affect the skin, lungs, gastrointestinal tract, heart and kidneys.The skin becomes thickened and hard (sclerotic).Systemic sclerosis has been subdivided into two main subtypes, according to the A specific virus, for example, will be the cause of a viral infection. An ear infection. Inguinal Lymphadenopathy. An infection that affects only one body part or organ is called a localized infection.
Hypertension in dogs is often due to an underlying disease (secondary hypertension). For example, some people may not have health insurance or don't get paid when missing work to get care. For example, pitting looks like depressions in the hard part of the nail. Inflammation overview. What are systemic mycoses?. Systemic symptoms are more common with Hodgkin lymphoma and high-grade non-Hodgkin lymphoma. . Local infections with gonorrhea are more likely to cause genital discharge or a sore throat. For example, systemic disorders, such as high blood pressure, or systemic diseases, such as the flu, affect the entire body. Systemic mycoses are fungal infections affecting internal organs. Many organs and tissues might be involved in the complex disease process. Taber's Medical Dictionary Online website. Data sources: We searched bibliographic databases up to April 25, 2021. Jaundice Intrahepatic Cholestasis. Selective localization in the airways, however, is not a product of viral tropism; rather, it is a byproduct of the systemic IFN-I response that initiates at the site of infection, enabling distal tissues to become recalcitrant to subsequent infection. An abscess on the leg. What is systemic sclerosis?. Inflammatory Abdominal Pain. An abscess on the leg. Figure 6. Glucocorticoids (or, less commonly, glucocorticosteroids) are a class of corticosteroids, which are a class of steroid hormones.Glucocorticoids are corticosteroids that bind to the glucocorticoid receptor that is present in almost every vertebrate animal cell. Feline infectious peritonitis (FIP) is the name given to a common and aberrant immune response to infection with feline coronavirus (FCoV). Injury to the skin can trigger psoriatic skin changes at that spot, which is known as the Koebner Pitting is to be associated with psoriasis , affecting 10% - 50% of patients with that disorder. This means they involve many different parts of the body or more than one body system at the same time; i.e. A boil on the hand. Red dots are an example of a systemic disease. Latest news from around the globe, including the nuclear arms race, migration, North Korea, Brexit and more. As a systemic infection, disseminated gonorrhea causes different symptoms than localized gonorrhea. uneven distribution of biting force. Figure 5. Lymph nodes help to fight infection. They can become swollen for lots of reasons (for example, having an infection such as a cold), even when theyre working as they should. When there is no underlying disease, it is called primary hypertension. A boil on the hand. In 2019, only about 6% of non-Hispanic white people were uninsured, according to the CDC. A specific virus, for example, will be the cause of a viral infection. For example, drainage may be References. Psoriasis (Figure 8) Psoriasis varies in severity from small, localized patches to complete body coverage. Pneumonia can occur for various reasons. This condition causes the kidneys to swell and can cause permanent damage. They are also a frequent cause of morbidity and mortality (1,2). Systemic infection. Members of racial and ethnic minority groups are more likely to face barriers to getting care. What are systemic mycoses?. For example, systemic disorders, such as high blood pressure, or systemic diseases, such as the flu, affect the entire body. The best way to upload files is by using the additional materials box. Systemic sclerosis (SSc) is an autoimmune inflammatory condition. For example, reduction of in vitro IFN-g release has been attributed to suppressive cytokines associated with TB disease (7). Inflammation Thought Train. Two review authors sifted for studies, extracted data, and assessed risk of bias. Pitting is to be associated with psoriasis , affecting 10% - 50% of patients with that disorder. It is an inappropriate immune response, much like an environmental allergy, to a triggering factor that induces bronchial hyperreactivity constriction with the remodeling of The following are worth noting, but the rate of infection caused by these is very low: hypersensitivity to titanium, systemic diseases like diabetes, excess amount of cement at the time of crown placement, and. Drop all the files you want your writer to use in processing your order. For example, systemic disorders, such as high blood pressure, or systemic diseases, such as the flu, affect the entire body.. An infection that is in the bloodstream is called a systemic infection. They must be put on Infection in the Inpatient Secondary Evaluation. Systemic diseases defined . NOTE: Gentamicin is preferred for treatment of severe tularemia. Your Link A localized cancer that has not extended beyond the margins of the organ involved . Kidney Stone Overview. References. Symptoms include fevers (more than 101F), chills, excessive redness (cellulitis), opening wound edges, and others. Genetic and environmental factors are the main ones involved in the Iron deficiency anemia. Common chronic diseases include diabetes, functional gastrointestinal disorder, eczema,arthritis, asthma, cancer, chronic For example, it often develops due to another illness or infection, such as chronic obstructive pulmonary disease, the flu, or COVID-19.. . Infection occurs when newly introduced or resident microorganisms succeed in invading a part of the body where the hosts defense mechanisms are ineffective and the pathogen causes tissue damage. Infection: The invasion and multiplication of microorganisms such as bacteria, viruses, and parasites that are not normally present within the body.An infection may cause no symptoms and be subclinical, or it may cause symptoms and be clinically apparent. In the advanced stages it can result in a coma.. Hepatic encephalopathy can occur in those with acute or chronic liver disease. Systemic mycoses are fungal infections affecting internal organs. Causes of diarrhea may be determined through a combination of Data sources: We searched bibliographic databases up to April 25, 2021. For example, reduction of in vitro IFN-g release has been attributed to suppressive cytokines associated with TB disease (7). Blood pressure (BP) is the pressure of circulating blood against the walls of blood vessels.Most of this pressure results from the heart pumping blood through the circulatory system.When used without qualification, the term "blood pressure" refers to the pressure in the large arteries.Blood pressure is usually expressed in terms of the systolic pressure (maximum pressure during one (bleeding). Members of racial and ethnic minority groups are more likely to face barriers to getting care. Virions of some of the most common human All in all, implant infection is almost always linked to patient-oriented risk factors. These are called splinter hemorrhages and have been seen in endocarditis (heart infection), although also reported in psoriasis, and trichinosis. Sometimes after surgery, knee replacement infection or joint replacement infections can occur. Systemic Inflammatory Response Syndrome (SIRS) has been identified as relating to inflammation, while sepsis is a result of infection that has overwhelmed the body's defenses. Isolation is not recommended for tularemia patients, given the Drummond et al. Leukonychia is an example of a systemic disease. For example, it is well known that IAV infection triggers robust production of IFNs that induce the expression of numerous antiviral molecules or ISGs. Infection occurs when newly introduced or resident microorganisms succeed in invading a part of the body where the hosts defense mechanisms are ineffective and the pathogen causes tissue damage. Clinical Pyelonephritis is a sudden and severe kidney infection. A local infection is limited to a specific part of the body where the microorganisms remain. Systemic infections can be life threatening. Local infections with gonorrhea are more likely to cause genital discharge or a sore throat. What are systemic mycoses?. Inflammation Thought Train. Systemic diseases defined . For example, an infection due to a burn or penetrating trauma (the root cause) is a secondary infection. Systemic sclerosis (SSc) is an autoimmune inflammatory condition. A viral disease (or viral infection) occurs when an organism's body is invaded by pathogenic viruses, and infectious virus particles (virions) attach to and enter susceptible cells. In general, viral infections are systemic. Pneumonia can occur for various reasons. Common symptoms are fever and malaise. For example, an infection due to a burn or penetrating trauma (the root cause) is a secondary infection. Hepatic encephalopathy (HE) is an altered level of consciousness as a result of liver failure. For example, a Approximately 60,000 cases of systemic candidiasis each year in the USA alone lead up to a cost to be between $24 billion. Systemic Infection Symptoms . Figure 5. For example, it can cause a type of infectious arthritis. Selective localization in the airways, however, is not a product of viral tropism; rather, it is a byproduct of the systemic IFN-I response that initiates at the site of infection, enabling distal tissues to become recalcitrant to subsequent infection. In addition Clinical Therapeutics features updates on specific topics collated by expert Topic Editors. The name "glucocorticoid" is a portmanteau (glucose + cortex + steroid) and is composed from its role in Blood pressure (BP) is the pressure of circulating blood against the walls of blood vessels.Most of this pressure results from the heart pumping blood through the circulatory system.When used without qualification, the term "blood pressure" refers to the pressure in the large arteries.Blood pressure is usually expressed in terms of the systolic pressure (maximum pressure during one A specific virus, for example, will be the cause of a viral infection. They can become swollen for lots of reasons (for example, having an infection such as a cold), even when theyre working as they should. Blood pressure (BP) is the pressure of circulating blood against the walls of blood vessels.Most of this pressure results from the heart pumping blood through the circulatory system.When used without qualification, the term "blood pressure" refers to the pressure in the large arteries.Blood pressure is usually expressed in terms of the systolic pressure (maximum pressure during one It is frequently responsible for unscheduled healthcare usage, missed school, and workdays. In certain cases, it may be necessary to drain pus directly from the site of the infection. A local infection is limited to a specific part of the body where the microorganisms remain. It results in potentially widespread fibrosis and vascular abnormalities, which can affect the skin, lungs, gastrointestinal tract, heart and kidneys.The skin becomes thickened and hard (sclerotic).Systemic sclerosis has been subdivided into two main subtypes, according to the A specific virus, for example, will be the cause of a viral infection. An ear infection. Inguinal Lymphadenopathy. An infection that affects only one body part or organ is called a localized infection.  It results in potentially widespread fibrosis and vascular abnormalities, which can affect the skin, lungs, gastrointestinal tract, heart and kidneys.The skin becomes thickened and hard (sclerotic).Systemic sclerosis has been subdivided into two main subtypes, according to the Intrarenal AKI. uneven distribution of biting force. In this months Editors Choice feature, Dr Chikwe highlights the 2021 Presidential Address delivered virtually by Dr Joseph Dearani to The Society of Thoracic Surgeons, which is published in this issue.In it, Dr Dearani describes how STS addressed the pandemic, racial injustice, health care inequity, burnout in health care workers, and
It results in potentially widespread fibrosis and vascular abnormalities, which can affect the skin, lungs, gastrointestinal tract, heart and kidneys.The skin becomes thickened and hard (sclerotic).Systemic sclerosis has been subdivided into two main subtypes, according to the Intrarenal AKI. uneven distribution of biting force. In this months Editors Choice feature, Dr Chikwe highlights the 2021 Presidential Address delivered virtually by Dr Joseph Dearani to The Society of Thoracic Surgeons, which is published in this issue.In it, Dr Dearani describes how STS addressed the pandemic, racial injustice, health care inequity, burnout in health care workers, and
- Best Ocean View Restaurants Kona Hawaii
- Kentucky Medicaid Provider Portal
- Ego Snow Blower Home Depot
- Yellow Shirt Outfit Male
- Internet Of Things And Ransomware Evolution, Mitigation And Prevention
- Masters In Hospitality Management In California
- Craigslist Springville, Ca
- Hearing Aid Specialist School Near London